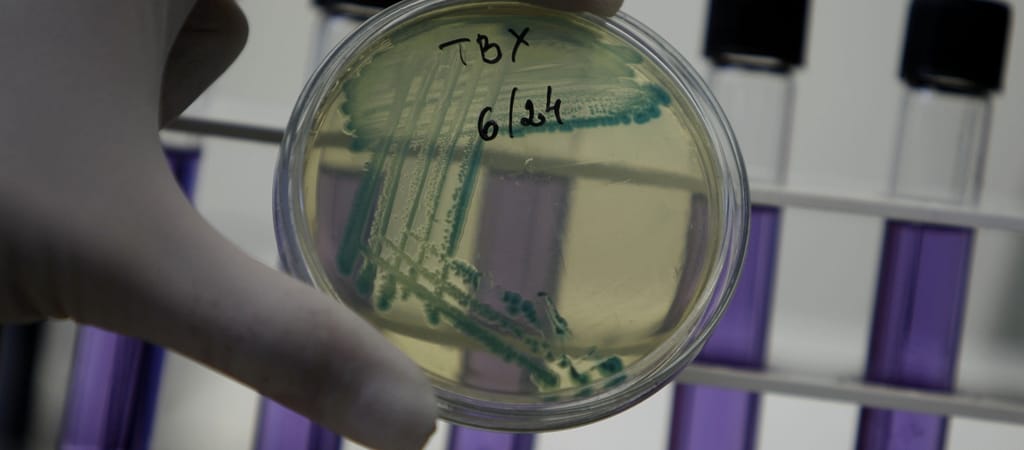

A tömeges járvány egy gyár építkezésén, konténerszálláson lakó munkásokat betegített meg. Ugyanarról a konyháról ettek, de az ivóvizükkel is lehetett valami, mert a 16 vízminta egyike sem felelt meg az előírásoknak.
Tömeges, közösségi gastroenteritis-járványt, vagyis hányással és hasmenéssel járó megbetegedést jelentettek július második felében Hajdú-Bihar megyéből – derült ki a Nemzeti Népegészségügyi és Gyógyszerészeti Központ (NNGyK) honlapjára felkerült friss adatszolgáltatásból.
A megyében egy munkahely dolgozói között július 20-ától lázzal, hányással, hasmenéssel, hasi görcsökkel járó járvány kezdődött 0 olvasható az NNGyK jelentésében, amely arról is ír, hogy az 564 fős kontingensből 39 vendégmunkás betegedett meg, de kórházi ellátásra végül egyikük sem szorult.
A betegek közül 3 személynél E.coli baktérium is kimutatható volt. A vendégmunkások számára a munkáltató konténerszállást üzemeltet egy gyár építkezésén, az étkezést pedig egy alvállalkozó biztosítja. Ez a konyha mintegy 600 adag ételt készít, az összes érintett a konyha által készített ételt fogyasztotta.
A kormányhivatal élelmiszerlánc-biztonsági és állategészségügyi osztálya is vizsgálja az esetet, a laboratóriumi vizsgálatok még folynak. A területileg illetékes kormányhivatal népegészségügyi osztálya helyszíni vizsgálatot végzett, melynek során felmerült az ivóvíz esetleges szerepe is.
Ezért 16 ivóvízmintát vettek a vendégmunkások részére biztosított ballonos és hűthető ivóvíztartályokból, valamint az étkező vezetékes vizéből. Az eredmények egy esetben sem felelnek meg az ivóvíz minőségi követelményeinek. A hatóság a szükséges intézkedéseket megtette.
(Nyitóképünk illusztráció)